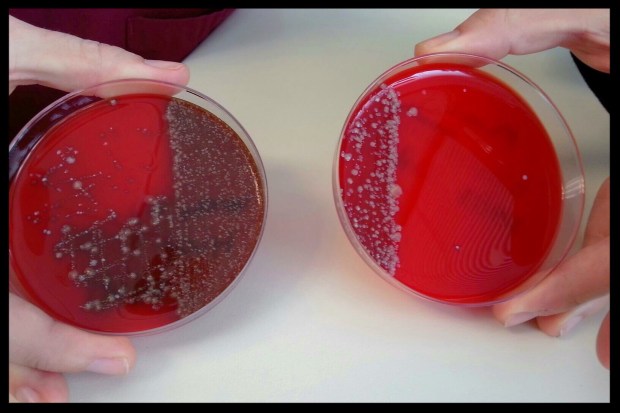

One of the most frequent topics to arise on reptile forums and Facebook groups is the subject of respiratory infections (RI). Not a single day goes by without at least one post in a group, or at least one PM or e-mail to me, seeking advice regarding a snake that is ill with an RI and what to do about it. Most often these are newer keepers that do not yet understand reptile diseases, but there are also still many established hobbyists whose automatic approach to an RI is to raise temps & humidity and self-administer Baytril or Tylan that they purchased at a farm store. Unfortunately these hobbyists then recommend this same approach to the new keepers, and that is where the damage lies.
The big problem with this outdated practice, aside from creating antibiotic-resistant strains of bacteria and the nephrotoxic side effects of Baytril, is that not every RI has the same underlying cause. Many are bacterial, with pseudomonas bacteria and mycoplasma bacteria being among the most common.
A novel Mycoplasma sp. associated with proliferative tracheitis and pneumonia in a Burmese python (Python molurus bivittatus).
However, there are thousands of different types of bacteria surrounding our reptiles at any given moment, each one causing a different strain of RI that then requires a specific class of antibiotic to treat it. Not every antibiotic is effective against the same type of bacteria!
For example, if your snake has an RI that is being caused by a strain of bacteria that is only susceptible to cephalosporins such as Ceftazidime or Cefalexin, and is resistant to fluoroquinolones — you giving it Baytril (which is Enrofloxacin, a type of fluoroquinolone) is going to do nothing for that snake but waste time, risk kidney damage and tissue scarring, put more strain on his/her system, and potentially make the infection worse or cause a secondary opportunistic infection.
In order to properly treat that bacterial RI, you need to have a tracheal swab or lung wash taken and a culture completed by a qualified reptile vet:
Swabs of human (L) and dog (R) mouths grown on blood agar plates for 48 hours. Image Credit: Jen Whitaker
Culture: The cultivation of bacteria, tissue cells, etc. in an artificial medium containing nutrients. [1]
A culture will show what type of bacteria grows, and will determine if there are any abnormal strains present. This needs to be followed by a sensitivity screen (i.e. Kirby-Bauer disk diffusion test), which will tell you precisely what class of antibiotic will be most effective against that strain of bacteria. These tests will cost some money, but overall you will SAVE money, as well as precious time and the health of your snake by treating with the correct antibiotic and the correct dosage the first time around.
That said, not all RI can be treated with antibiotics as not all RI are bacterial — and that is something it seems most reptile hobbyists still don’t seem to know or understand. That is why a culture should always be the first step — to potentially rule out bacterial cause. In addition to bacterial, RI can also be fungal, albeit rarely, and can also be viral. Viral means it is caused by a virus; influenza, herpes, rabies, and the common cold are all viruses in humans. Snakes also have viral families like these. There are several well known viruses that affect commonly-kept pet species such as ball pythons (Python regius), Burmese pythons (Python bivittatus), and red-tailed boa constrictors (Boa constrictor imperator), as well as various zoological specimens.
Most hobbyists are generally aware of Inclusion Body Disease (IBD) and that this disease is fatal with no cure. IBD is caused by an arenavirus called reptarenavirus, and causes inclusion bodies inside the cytoplasm of various body cells. [2]

An inclusion body to the left of the nucleus inside the cytoplasm of a snake heterophil at 100x. Image Credit: Jen Whitaker
In the past, it could only be diagnosed via post-mortem histology on tissue samples sent out after necropsy. Veterinary medicine has since made significant advancements, and thanks to Dr. Elliott Jacobson and his team at the University of Florida, there is now a PCR test available for IBD.
“Polymerase chain reaction (PCR) is an efficient and cost-effective way to copy or “amplify” small segments of DNA or RNA.
Using PCR, millions of copies of a section of DNA are made in just a few hours, yielding enough DNA required for analysis. This innovative yet simple method allows clinicians to diagnose and monitor diseases using a minimal amount of sample, such as blood or tissue.
In addition to detecting diseases in a sample, PCR enables the monitoring of the amount of a virus present, or viral load, in a [living] body.” [3]
It can be run on blood taken from a living specimen in order to confirm or rule out IBD. A sample can be sent to the University of Florida diagnostics lab or to ZooPath through a qualified reptile DVM.
Ophidian Paramyxovirus (OPMV or PMV) is lesser known among the reptile community despite being a relatively common virus that causes severe RI in a variety of snake species worldwide from colubrids to boids to vipers, and is generally fatal. In 1972, an outbreak of RI in a Swiss serpentarium led to the initial discovery of PMV, followed in 1979 by another outbreak in a private collection in the U.S. [4] Since then there have been over 50 published reports about reptile paramyxoviruses from all over the world. These are just the academically published papers and case studies, and don’t include the hundreds of other outbreaks and infections that occurred in private collections or pet homes and were tested/diagnosed as any other case through a veterinarian. The primary strain mentioned in these cases was the Ferlavirus; named for the species in which it was first identified — the fer-de-lance. [4] There have been numerous other strains as this virus mutates and evolves, similar to its influenza cousin in humans.
In 2012, a new, highly divergent, extremely fatal strain of PMV called Sunshine Virus, was described in a collection of over 70 Morelia spp. in a collection on Australia’s Sunshine Coast (hence the virus’ name), and the virus has quickly begun destroying collections throughout the country:
Recommended quarantine against SV is a minimum of 18 months, as that is the longest that an infected carrier has been known to remain asymptomatic. Currently there have been no confirmed cases of Sunshine Virus outside Australia and Germany. However, multiple collections in Europe and the U.S. have dealt with their own PMV outbreaks among multiple species, and several published papers have identified a carrier state when snakes from established collections were tested. [5] There are currently blood serum PCR tests available for 3 identified and mapped strains of PMV in the U.S., and these can be conducted via ZooPath, Avian & Exotics Clin Path Lab, and several university labs. Veterinary labs like Antech also offer these tests through a qualified reptile veterinarian.
In September 2014, I was made aware by Dr. Shane Simpson (probably the most well-known and respected DVM in Australia) of a brand new paper published September 9th, 2014 regarding a newly-sequenced but long-known virus linked to severe and often fatal respiratory infection in ball pythons, labeled Ball Python Nidovirus (BPNV). This was an ongoing study using samples taken from 7 collections around the U.S. from 2006 to 2013:
Ball Python Nidovirus: a Candidate Etiologic Agent for Severe Respiratory Disease in Python regius

My first ball python, Spoon. He had the sweetest personality. Image Credit: Jen Whitaker
I myself used to breed a moderately sized variety of snake species, mostly ball pythons. I lost my original collection of ball pythons to an aggressive, deadly viral RI in 2007-2008. No one knew what it was at the time, and it was a battle to get answers. It was originally thought by the University of Florida to be a new strain of possible Paramyxovirus whose DNA they had never sequenced before. As it turns out, it was not PMV, but was instead one of the first contributors to the identification of BPNV.
My former reptile veterinarian, Dr. Marc Gordon, is one of the research partners of the paper published in September, and he was the one that handled the viral epidemic in my original collection. In the paper’s description regarding the snakes used in the study, it specifically mentions 3 from a private collection in Wisconsin — which were my snakes. All of the details confirmed the work Dr. Gordon did on my case and the observations we made, including the 2 living sick snakes we chose to euthanize in order to get fresh tissue samples from:
“Three ball pythons (5, 6, and 7) from a private collection in Wisconsin were submitted to a veterinarian due to signs of respiratory disease. Ball python 5 was found dead and submitted for necropsy. The following tissues were collected, fixed in NBF, and processed for light microscopy: lungs, kidney, liver, stomach, spleen, and ovary with oviduct. Ball pythons 6 and 7 had acute onset of respiratory signs over a 2- to 3-day period characterized by an increase in respiratory rate and effort. There also was elevation of the cranial third of the snake’s body (from the ground), ultimately resulting in opisthotonos (stargazing). A decision was made to euthanatize and necropsy BP6 and -7.” [6]
Thus this information changed the previously accepted theory that my collection was destroyed by Paramyxovirus — up until that point, thought to be potentially the first U.S. case of Sunshine Virus (before it had been sequenced), and instead was confirmed to have been BPNV.
Nidoviruses are also being found in other species, ranging from carpet pythons to green tree pythons to boas, and even in wild shingleback lizards. [7][8][9] This is why it is so vital to have a necropsy performed on any deceased animal, and to have a culture and/or PCR performed — especially when any symptoms of an extremely deadly and communicable virus are present. Even if tests comes back negative, or as something easily treatable, it at least rules out potentially serious pathogens that can destroy multiple animals or entire collections/populations.
There are two sections of the BPNV paper that I strongly feel should be noted. The first is regarding today’s methods of herpetoculture creating a breeding ground and transmission vector for viruses like BPNV:
“Current standards in herpetoculture encourage disease transmission and may foster evolution of increased pathogen virulence. Captive snake breeding operations typically operate at high stocking densities, and breeders commonly attend trade shows, where animals from different sources are juxtaposed. In addition, animals from geographically and ecologically diverse areas are commonly imported and mixed with minimal quarantine. These practices increase pathogen exposure and lower barriers to transmission.” [10]
The second section I’d like to reference is regarding the prevalence of viruses like this in the reptile community with little open discussion or effort toward transparency. The 7 collections listed in this paper were all confirmed to have been BPNV. I was one of 11 known victims of the seller that spread the virus to me, and none of the other 10 contributed to this study, all of whom lost their animals. That makes 17 known cases/outbreaks of BPNV — and the 10 other victims in my case were just the ones that went public, including a DVM from Colorado. The seller, Damian Wyatt, sold hundreds of snakes all over the country and to Europe as he dumped his collection off in 2007 and 2008.
The information in the paper on BPNV shows that even large breeders (74+ snakes in Pennsylvania and 500+ snakes in Oklahoma at the time of this study) have these contagious viral respiratory infections in their collections:
“Ball python 11 was a 6-year-old adult from a private collection in Pennsylvania. The owner had about 74 snakes in total, all of which were ball pythons. Seven snakes in close proximity to one another from his collection became sequentially ill with clinical signs of respiratory disease, including dyspnea and open-mouth breathing, All ill snakes were immediately quarantined in a separate room from the general population. Of the 7 snakes that became ill, 6 died within a few days of first manifesting signs of respiratory disease. One of the dead snakes was submitted to a private practitioner for necropsy.”
“The second case (BP10) was a 5-year-old female common BP from a large collection (500-plus) of ball pythons in Oklahoma. Prior to 2009, no significant health issues were recognized in this collection. Starting in 2009 several ball pythons showed signs of respiratory disease, and from 2010 to early 2011, three ball pythons died with clinical signs of respiratory disease. Ball python 10 had signs of respiratory disease and was euthanized for pathological evaluation.” [11]
Thus the importance of strict quarantine, regardless of who you purchase from. Ideally all new purchases should be quarantined for 4-6 months, in a separate building from the established collection with separate tools, equipment, feeder sources, etc. It can be as simple as keeping new animals at work, your parents’ house, your friend’s house, or your significant other’s home. If a separate building is not manageable, then a separate room as far away from the established collection is second choice, preferably with separate ventilation. Always work with your established animals first, before moving on to your quarantine animals. Never go back to permanent collection after working in quarantine, even if hours have passed. Sanitize yourself or shower/change clothes if possible when leaving your quarantine area. Never share tools or supplies or caging between the two sections. When a new animal comes into quarantine, any other animals still present that haven’t moved to the permanent collection yet have to have their time reset, or at the least extended by 3 months to ensure the new addition did not bring anything in that they could transmit to the established animals. Incubation time varies per individual animal, from days to months, which means they may be infected without showing symptoms yet. When in doubt, always err on the side of caution.
These procedures may seem like overkill, but when you’ve seen entire collections get wiped out by incurable viruses, causing people to lose their pets, their hard work, their investments, and in some cases their livelihoods — these quarantine procedures will be lifesavers.
As a community, reptile hobbyists and breeders need to push forward as a whole and force in a new mentality to seek qualified veterinary care. Cultures and diagnostics, more specific pinpointed treatment, viral PCR testing, and histopathology/necropsies are never, ever a waste of money. They are better medicine, and the knowledge gained contributes to the research and overall knowledge of the diseases these animals face — allowing veterinary medicine to keep advancing and one day find a cure.

What a timely piece now! Thank you so much for such a good post.
I saw your books earlier, but this one I believe on of the
the best, same as this one https://kunenerak.org/. How did you find so many facts?
I like how you organize everything, since it’s really easy to read.
All in all, I can recommend this guide to everyone who’s interested
in that topic.
LikeLike